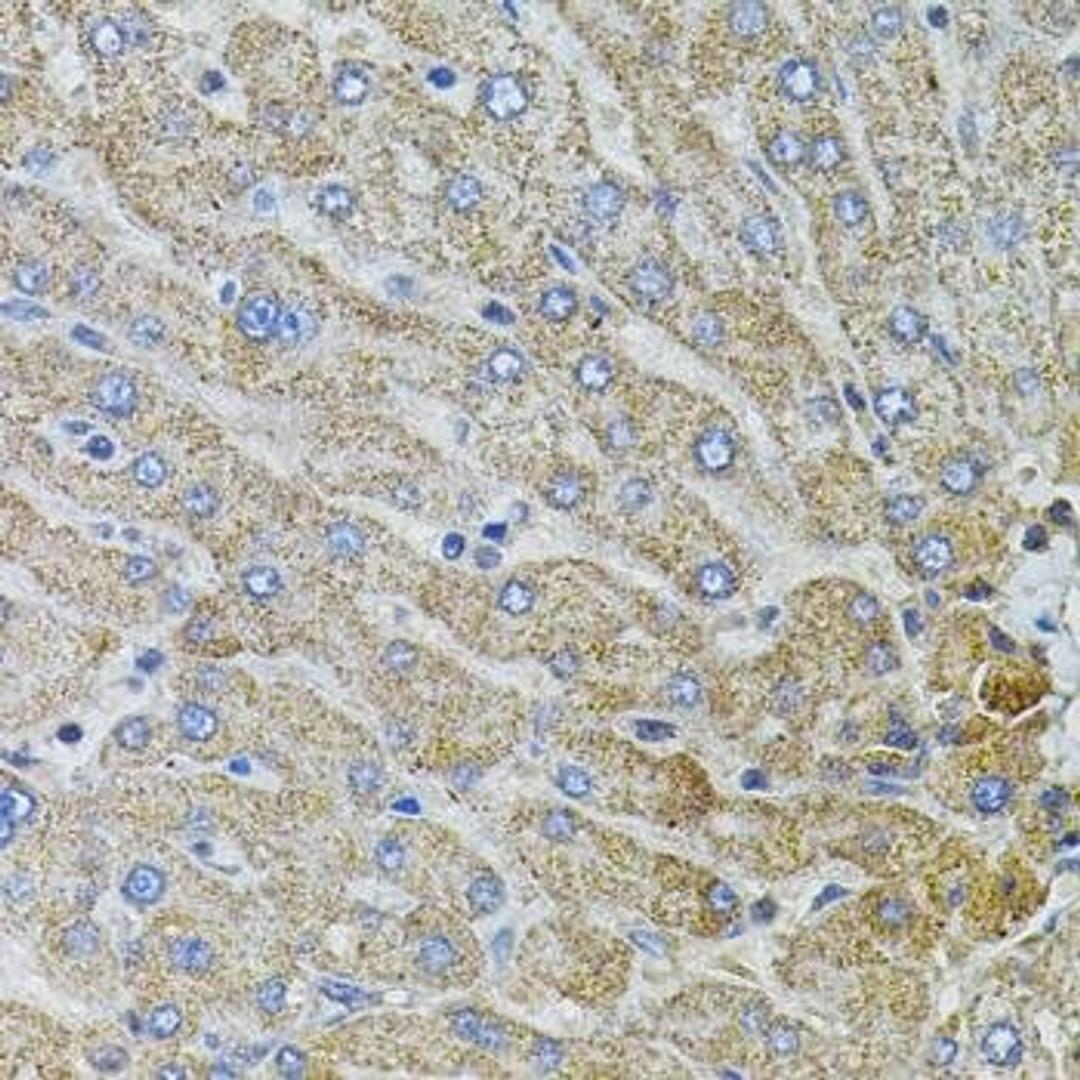

Product & ReviewsAntibodies
ARID2 antibody
Product Details
- Cat. No.
- orb374216
- Type
- Primary Antibody
- Clonality
- Polyclonal
- Host
- Rabbit

The supplier does not provide quotations for this antibody through SelectScience. You can search for similar antibodies in our Antibody Directory.
Description
Rabbit polyclonal antibody to ARID2
Biological Information
- Clonality: Polyclonal
- Host: Rabbit
- Reactivity: Human
- Isotype: IgG
- Gene: 85569
Handling
- Quantity: 500 µg, 100 µg, 200 µg
- Storage: Store at -20°C to -70°C. Reconstituted antibody can also be aliquotted and stored at 4°C for one month or at -20°C to -70°C in a manual defrost freezer for many months without detectable loss activity. Please avoid freeze-thaw cycles.
- Buffer: Supplied as a powder obtained from lyophilization of purified antibody in PBS without preservatives. Reconstitute the antibody with sterile 1 x PBS to a final concentration of 1 mg/ml.
Applications
- Western Blotting (WB)